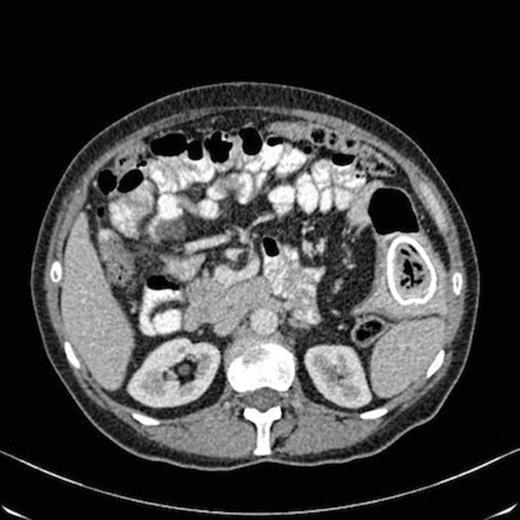
CT scan showing oval calcification in a segment of the small bowel in the left flank situated within a diverticulum with thickening of the small bowel wall at that level

-
PDF
- Split View
-
Views
-
Cite
Cite
U Ihedioha, S Panteleimonitis, M Patel, A Duncan, GJ Finch, An unusual presentation of Meckel's diverticulum, Journal of Surgical Case Reports, Volume 2012, Issue 3, March 2012, Page 4, https://doi.org/10.1093/jscr/2012.3.4
Close - Share Icon Share
Abstract
Meckel's diverticulum can present with unusual symptoms and signs and therefore delay diagnosis. We present the case of a 63 year old lady who presented to the gynaecologists with a huge right sided ovarian cyst. She had required 13 units blood transfusion previously (5 years ago) for massive gastrointestinal bleed with no cause found despite extensive investigations. At operation she was found to have a Meckel's diverticulum in the left lumbar region containing a large calculus. She had an unremarkable post-operative course.
INTRODUCTION
Meckel's diverticulum is the most common congenital anomaly of the gastrointestinal tract. It occurs in about 2% of the population and often difficult to diagnose. The condition was first described by Fabricius Hildanus in 1598 but derives its name from a German anatomist Johann Friedrich Meckel who described the embryological and pathological features (1). The majority of cases are asymptomatic while the symptomatic cases mimic common abdominal conditions such as appendicitis, Crohn's disease and peptic ulcer disease (2). The lifetime risk of developing complications in a person with Meckel's diverticulum is 4-6% (1). The most common complication is gastrointestinal bleeding which occurs in 25 to 50 % of patients. Others are obstruction, intussusception, diverticulitis and perforation (3).
The presence of calculi in Meckel's diverticulum is rare. Kusomoto et al (4) reviewed the records of 776 patients with Meckel's diverticulum and found stones in only 2 of the patients.
Calculi in a Meckel's diverticulum located in the left lumbar region have not been reported, but we describe such a case.
CASE REPORT
A 63 year old lady was referred to the gynaecology outpatient department by her General Practitioner with a 4 week history of abdominal distension, bloating, weight gain and constipation. Blood tests had revealed an elevated CA 125(53). There was no history of postmenopausal bleeding. She had required a 13 unit blood transfusion 5 years ago due to a massive gastrointestinal bleed for which no cause was found, despite extensive investigations. Other relevant past history included appendicectomy and cholecystectomy.
On review by the gynaecologist, clinical examination revealed a normal lower genital tract and cervix with a 12-14cm right adnexial mass and no involvement of the pouch of douglas. A transabdominal and transvaginal ultrasound scan was requested which revealed a 12 cm complex right ovarian cyst with a 3 cm daughter cyst. A CT scan was therefore requested which revealed a large cystic mass within the abdomen and pelvis with solid mural component with invasion of the uterus. There was also finding of an oval calcification in a segment of the small bowel in the left flank situated within a diverticulum with thickening of the small bowel wall at that level (Fig 1).
CT scan showing oval calcification in a segment of the small bowel in the left flank situated within a diverticulum with thickening of the small bowel wall at that level
Following discussion at the multi-disciplinary team meeting, the cyst was thought to be most likely benign or borderline but due to a small risk of underlying malignancy, laparotomy was indicated.
A General Surgeon was invited by the Gynaecologist during laparotomy. Findings were a 20 cm right ovarian cyst and a solid inflammatory 6cm mass within a Meckel's diverticulum with significant cicatrisation of the mesentery (Fig 2). A small bowel resection was therefore done. Pathology report confirmed the presence of a calculi within a Meckel's diverticulum. She made a good recovery and was discharged home 3 days after the operation.

Operative image showing a solid inflammatory 6cm mass within a Meckel's diverticulum
DISCUSSION
Meckel's diverticulum is a remnant of the omphalomesenteric duct which is normally obliterated by the 5th to 8th week of gestation. It is a true diverticulum of the ileum containing all three layers of the bowel wall and arises from the antimesenteric border of the bowel. It occurs in 2% of the population with only 2% becoming symptomatic and is found twice as often in males as in females.
Most authors describe patients with this condition presenting with pain in the right iliac fossa and mimicking acute appendicitis(5,6). Genevieve et al (7) conducted the largest series which described the CT findings on 11 patients with symptomatic Meckel's diverticulum. The diverticulum was located to the left of the midline in only one patient.
In our case the patient complained of pain in the left lumbar region which was the site of the diverticulum during surgery. We suspect that the huge right sided ovarian cyst could have pushed the small bowel to the left. This unusual location could have also contributed to the difficulty in diagnosis 5 years prior to the present diagnosis when she had massive gastrointestinal bleed.
Cases of stones in the small bowel are usually due to gallstone or foreign body. Calculi in a Meckels diverticulum are very rare (4,5,8,9). They were first described in 1852 and to date very few cases have been reported with 20-25% being radio-opaque (9). It is thought that formation of a calculi in a diverticulum could be explained due to stasis. Gin et al (10) described calculi formation in a blind pouch after side to side entero-anastomosis. We initially thought that the stone was from the gallbladder but examination of the biliary tree revealed no evidence of a fistula to the bowel and a previous cholecystectomy. The pre-operative liver function test and CT san did not reveal any biliary abnormality. This case serves as a reminder that gallstone like calculi can occur in a Meckel's diverticulum and erroneously implicate gallbladder pathology.
In conclusion, Meckel's diverticulum should be considered in patients presenting with left sided abdominal pain. This is even more so in patients who have had massive gastrointestinal bleed as this complication could be fatal if not diagnosed and treated early.